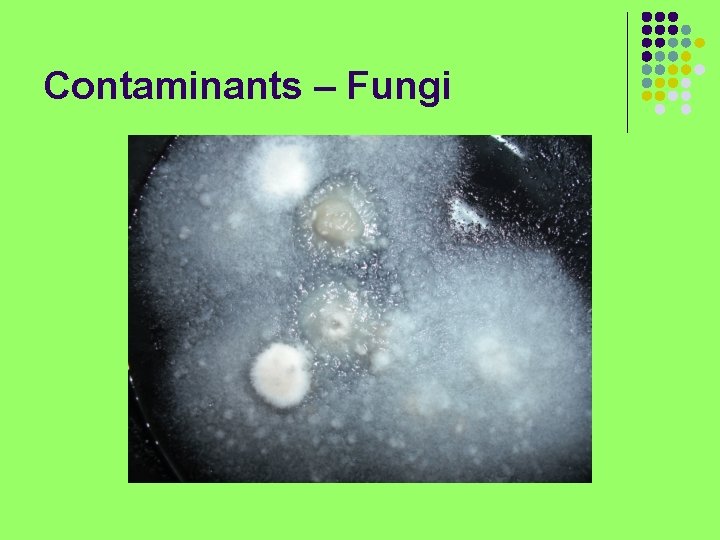
Contaminants – Fungi

Laboratory and Growth Room Conditions Sterile aseptic techniqueenvironment

Laboratory and Growth Room Conditions

Sterile (aseptic) technique/environment l Aseptic technique is absolutely necessary for the successful establishment and maintenance of plant cell, tissue and organ cultures. Why? l The in vitro environment in which the plant material is grown is also ideal for the proliferation of microorganisms. l In most cases the microorganisms outgrow the plant tissues, resulting in their death.

Sterile (aseptic) technique/environment l Contamination can also spread from culture to culture. l The purpose of aseptic technique is minimize the possibility that microorganisms remain in or enter the cultures.

Sterile (aseptic) technique/environment l The environmental control of air is also of concern because room air may be highly contaminated. l Example: Sneezing produces 100, 000 - 200, 000 droplets which contain a lot of microorganisms. l These contaminated particles may be present in the air for weeks. Air may also contain bacterial and fungal spores, as do we.

Contamination

Contaminants – Bacteria l Bacteria are the most frequent contaminants. l They are usually introduced with the explant and may survive surface sterilization of the explant because they are in the interior tissues.

Contaminants – Bacteria

Contaminants – Bacteria l Some bacterial spores can also survive the sterilization procedure even if they are on the tissue surface. l Bacteria can be recognized by a characteristic “ooze“. l The ooze can be many colors including white, cream, pink, and yellow. There is also often a distinctive odor.

Contaminants – Fungi l Fungi may enter cultures on explants or spores may be airborne. l Fungi are frequently present as plant pathogens and in soil. l They may be recognized by their “fuzzy” appearance, and occur in different colors.
Contaminants – Fungi

Contaminants – Virus l Viruses are extremely small organisms that are not easily detected. l Thus, plant culture is not necessarily pathogen-free even if microorganisms are not detected, and this can influence culture success. l Special measures such as meristem culture are often necessary to eradicate such contaminants.

Initial contaminants l Most contamination is introduced with the explant because of inadequate sterilization or just very dirty material. l Initial contamination is obvious within a few days after cultures are initiated.

Latent contamination l Contamination that is observed long after cultures are initiated is usually bacterial. l Apparently the bacteria are present endogenously in the initial plant material and are not obviously pathogenic in situ. l Latent contamination is particularly dangerous because it can easily be unknowingly transferred among cultures.

Introduced contamination l Contamination can also occur as a result of poor sterile technique or dirty lab conditions. l This kind of contamination is largely preventable with proper care.
- Slides: 14